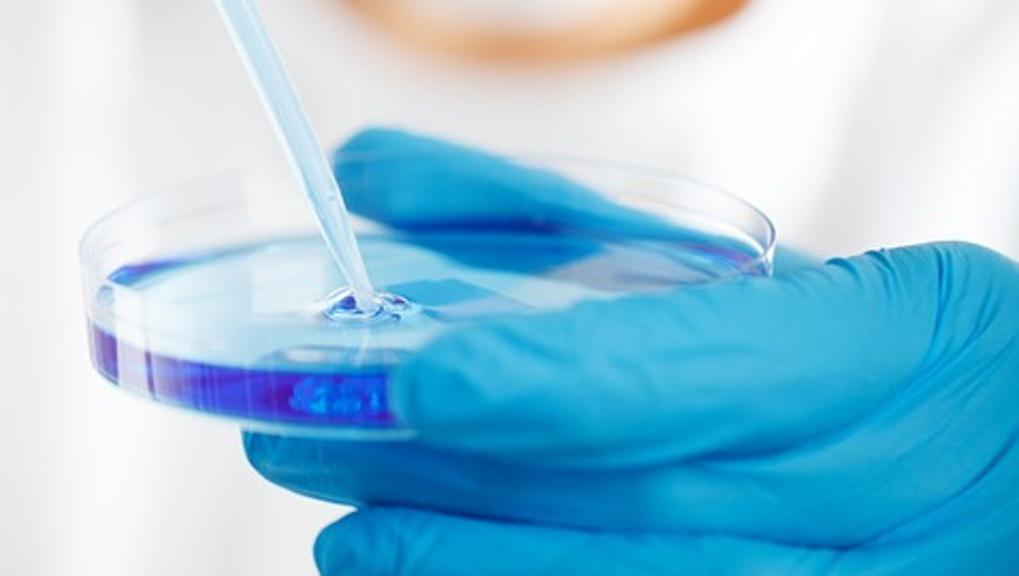

Oggi sempre più persone con melanoma metastatico sono vive ad anni di distanza dalla diagnosi. Uno scenario inimmaginabile sino al decennio scorso quando la malattia lasciava poche speranze. A cambiare radicalmente la situazione sono state l’immunoterapia e le terapie a bersaglio molecolare.
Come è cambiata la cura del melanoma grazie all’immunoterapia
«Prima dell’avvento dell’immunoterapia e dei farmaci a bersaglio molecolare – spiega la dottoressa Paola Queirolo, responsabile del Disease Management Team Melanoma e Tumori cutanei all’Ospedale Policlinico San Martino di Genova- il melanoma metastatico era affrontato con la sola chemioterapia e solo il 25% dei malati sopravviveva ad un anno dalla diagnosi».
Una situazione di impotenza che è cominciata a cambiare lentamente con l’avvento dei farmaci immunoterapici capaci di agire sui meccanismi che regolano il sistema immunitario. Da quel momento in poi è stato un susseguirsi di risultati positivi. Oggi grazie a questo approccio è possibile in molti casi tenere sotto controllo la malattia di fatto cronicizzandola.
Vivi a dieci anni di distanza dalla diagnosi
Il primo farmaco a rivoluzionare la terapia è stato ipilimumab: oggi, a distanza di 10 anni dalle prime somministrazioni, il 20% dei pazienti è ancora vivo. Un dato straordinario se si pensa che l’aspettativa di vita media era di soli 6-9 mesi con la chemioterapia.
A seguire sono arrivati in commercio altri anticorpi, come nivolumab e pembrolizumab, che hanno consentito di fare un salto ulteriore. Un esempio sono i dati appena resi noti al congresso ASCO relativi all’utilizzo di pembrolizumab come terapia in prima linea: l’86% dei pazienti con melanoma metastatico trattati con pembrolizumab mantiene la risposta dopo la sospensione del trattamento ma il dato più importante è quello relativo alla sopravvivenza. A 5 anni infatti è vivo il 41% dei pazienti.
Non solo immunoterapia: le terapie a bersaglio molecolare funzionano
Ma i buoni risultati dell’immunoterapia non devono fare dimenticare che i grandi progressi riguardano anche le terapie a bersaglio molecolare.
«Circa il 50% dei melanomi -spiega la Queirolo- contiene una mutazione nel gene BRAF. Questa caratteristica può essere sfruttata per utilizzare dei farmaci in grado di agire sul difetto genetico che porta alla malattia». Negli anni sono stati sviluppati diverse molecole come vemurafenib e econrafenib che come per l’immunoterapia hanno cambiato radicalmente le prospettive.
Un esempio? In uno studio presentato ad ASCO si è dimostrato che la combinazione di encorafenib e binimetinib è in grado di migliorare significativamente l’aspettativa di vita rispetto all’utilizzo del solo vemurafenib, un farmaco utilizzato da tempo nel trattamento dei melanomi con la mutazione di BRAF.
«Dalle analisi è infatti emerso che ad oggi, a 3 anni di distanza dall’inizio della sperimentazione, il 47% dei pazienti è ancora in vita rispetto al 32% del solo vemurafenib» conclude al Queirolo. Ma le novità non finiscono qui perché sono molti gli studi in cui si stanno sperimentando più combinazioni possibili delle diverse armi a disposizione e i risultati confermano che il melanoma sta diventando sempre più una malattia cronica.
FONTE LA STAMPA